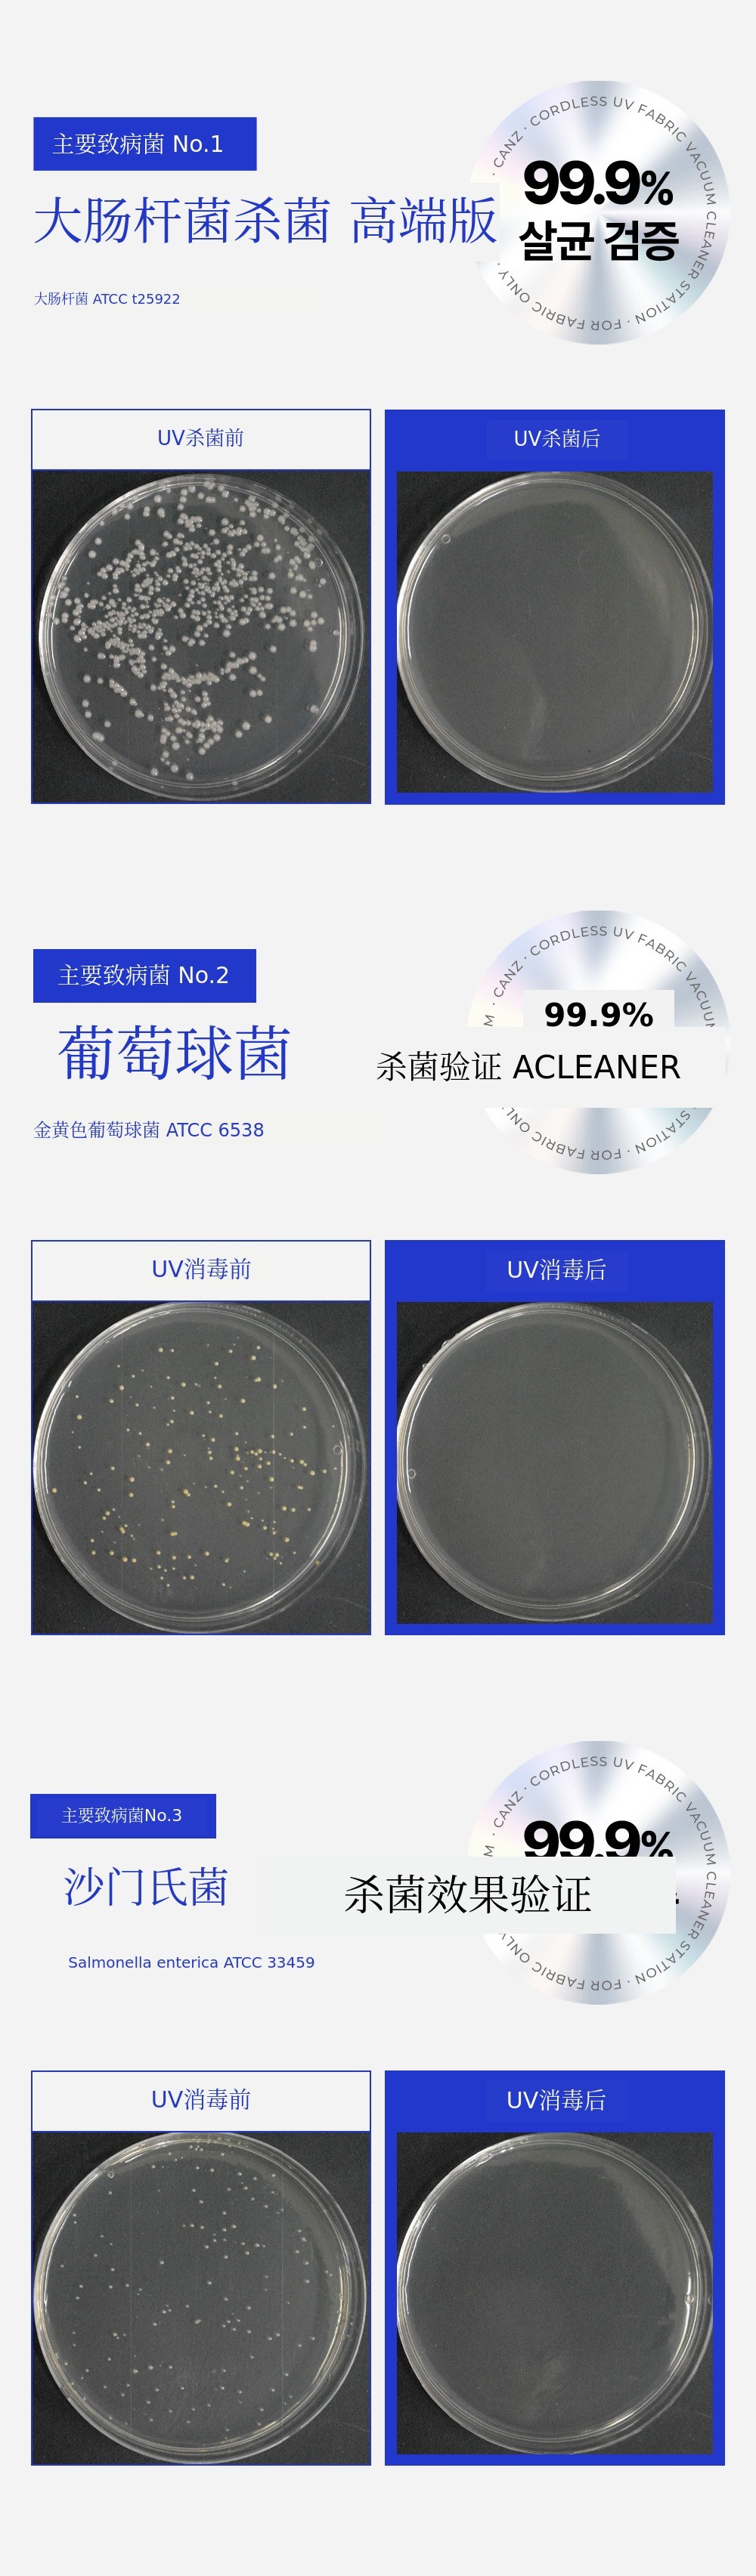

每当季节更替,每天早上醒来时反复打喷嚏和鼻塞。
已经在这种不适中生活了十多年。
当然,一般的吸尘器是无法解决的。
那段经历就是我们的起点。
基于亲自使用多种床上用品清洁机时感受到的局限性,我们决定开发一款真正适合床上用品结构的产品。
就这样,经过三年的不断改进,
亲自使用并开发出来的成果,就是现在介绍的自动清空床上用品清洁机。
尤其引以为傲的功能是自动滤网清洗。
为了防止头发缠绕,对滤网结构 进行了数十次修改,
虽然在技术上实现并不容易,但最终还是完成了专利注册。
一台产品即可实现自动清空、自动滤网清洗、UV双重杀菌 等所有功能,
将床上用品清洁所需的所有功能都集于一身。
每天只需轻轻推过床上用品,舒适就会成为日常。。
现在,危险的床上用品灰尘,不要再用手去碰了。
只需轻松一推,每天床上用品都像新的一样舒适。
请务必亲自体验,愿您在舒适的床铺上开始和结束美好的一天。
谢谢。
为什么选择Wadiz?
多亏了7000多位支持者的信任与陪伴,
我们实现了20亿的累计销售额和众多众筹经验。
这次的床上用品清洁器,凝聚了我们所有的时间和努力,是一份真诚的成果。
因此,我们希望您能最先体验‘床品清洁的新世界’。想要与大家一起分享。
我们会让您每天躺下的地方变得更加舒适。
请最先加入我们!


发货方式 快递(每日最多发货量:500件)
快递公司 CJ大韩通运
运费 3,000韩元(发货时间根据奖励数量可能有所变动,如有变动将通过最新消息提前通知。)
偏远地区发货说明
济州及偏远岛屿地区,请额外选择济州及偏远地区运费。
产品及配送相关咨询
-[联系制造商] 或发送邮件至 Inttech7@naver.com。
-关于快递休息期间,所有法定节假日及周日快递公司休息,敬请知悉。
-客户中心 031-945-8695 / 咨询时间 周一至周五 10:00~18:00
支付方式 咨询 Wadiz 客服中心 1661-9056
A/S客户中心 031-945-8695 / 咨询时间 工作日(周一至周五)10:00~18:00
1. 奖励收货后7天内,产品本身存在缺陷时适用Wadiz退款政策。
2. 因产品缺陷导致返还成功款项时,所产生的费用由制造商全额承担。
3. 因支持者故意或过失导致产品损坏或丢失时,不提供免费A/S服务。
4. 产品已组装或使用螺栓的情况下,无法退货。
有偿保修的情况
即使在保修期内,出现以下情况时也会产生费用。
1. 因液体渗入或异物吸入导致的损坏
2. 因跌落或冲击导致的损坏或故障
3. 因挥发性溶剂(如稀释剂、苯)导致的外观损坏
4. 因非正品零部件/耗材导致的故障
5. 使用错误电压
6. 未经授权拆卸导致的零件丢失/损坏
7. 未经官方授权的第三方维修/改装
8. 因自然灾害导致的损坏
9. 未遵守安全指引的情况
10. 未安装滤网/耗材情况下的操作
11. 不当使用或缺乏维护
支持者须知
- 奖励选项/收货地址/银行卡信息可在众筹截止日前,于我的Wadiz > 参与众筹 > 众筹记录页面进行修改。
- 众筹 截止 之后 不可避免的 原因 收货地址 需要变更 时 分钟 该 页面 内 给制造商 咨询 通过 请咨询。
LNT tech Co.,LTD
